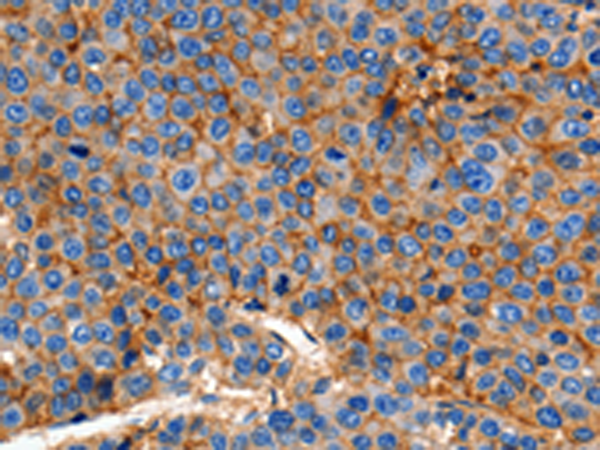

|
Background: |
Tight junctions represent one mode of cell-to-cell adhesion in epithelial or endothelial cell sheets, forming continuous seals around cells and serving as a physical barrier to prevent solutes and water from passing freely through the paracellular space. These junctions are comprised of sets of continuous networking strands in the outwardly facing cytoplasmic leaflet, with complementary grooves in the inwardly facing extracytoplasmic leaflet. The protein encoded by this gene, a member of the claudin family, is an integral membrane protein and a component of tight junction strands. Loss of function mutations result in neonatal ichthyosis-sclerosing cholangitis syndrome. |
|
Applications: |
ELISA, WB, IHC |
|
Name of antibody: |
CLDN1 |
|
Immunogen: |
Synthetic peptide of human CLDN1 |
|
Full name: |
claudin 1 |
|
Synonyms: |
CLD1, SEMP1, ILVASC |
|
SwissProt: |
O95832 |
|
ELISA Recommended dilution: |
1000-10000 |
|
IHC positive control: |
Human esophagus cancer and Human cervical cancer |
|
IHC Recommend dilution: |
100-300 |
|
WB Predicted band size: |
23 kDa |
|
|
|
|
WB Positive control: |
Hela cells |
|
WB Recommended dilution: |
1000-3000 |

購(gòu)物車(chē)
購(gòu)物車(chē) 幫助
幫助
 021-54845833/15800441009
021-54845833/15800441009
